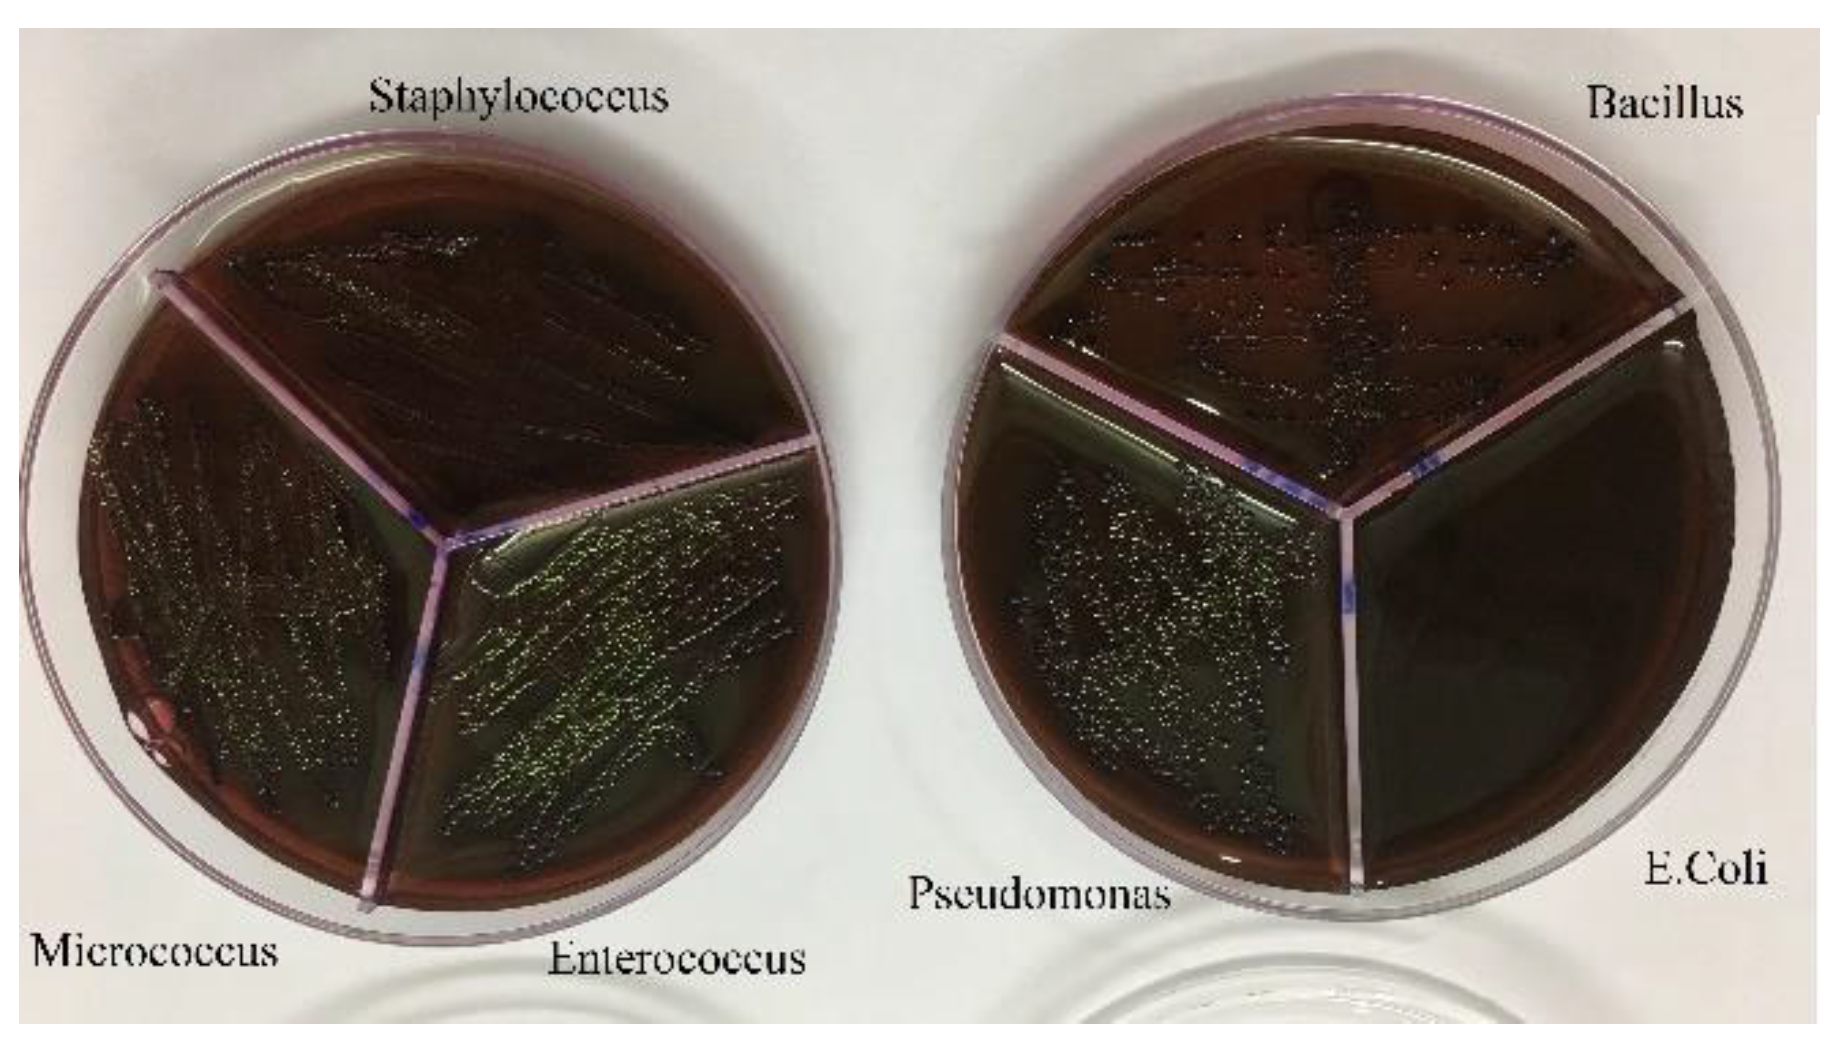
Preprints 85306 g006
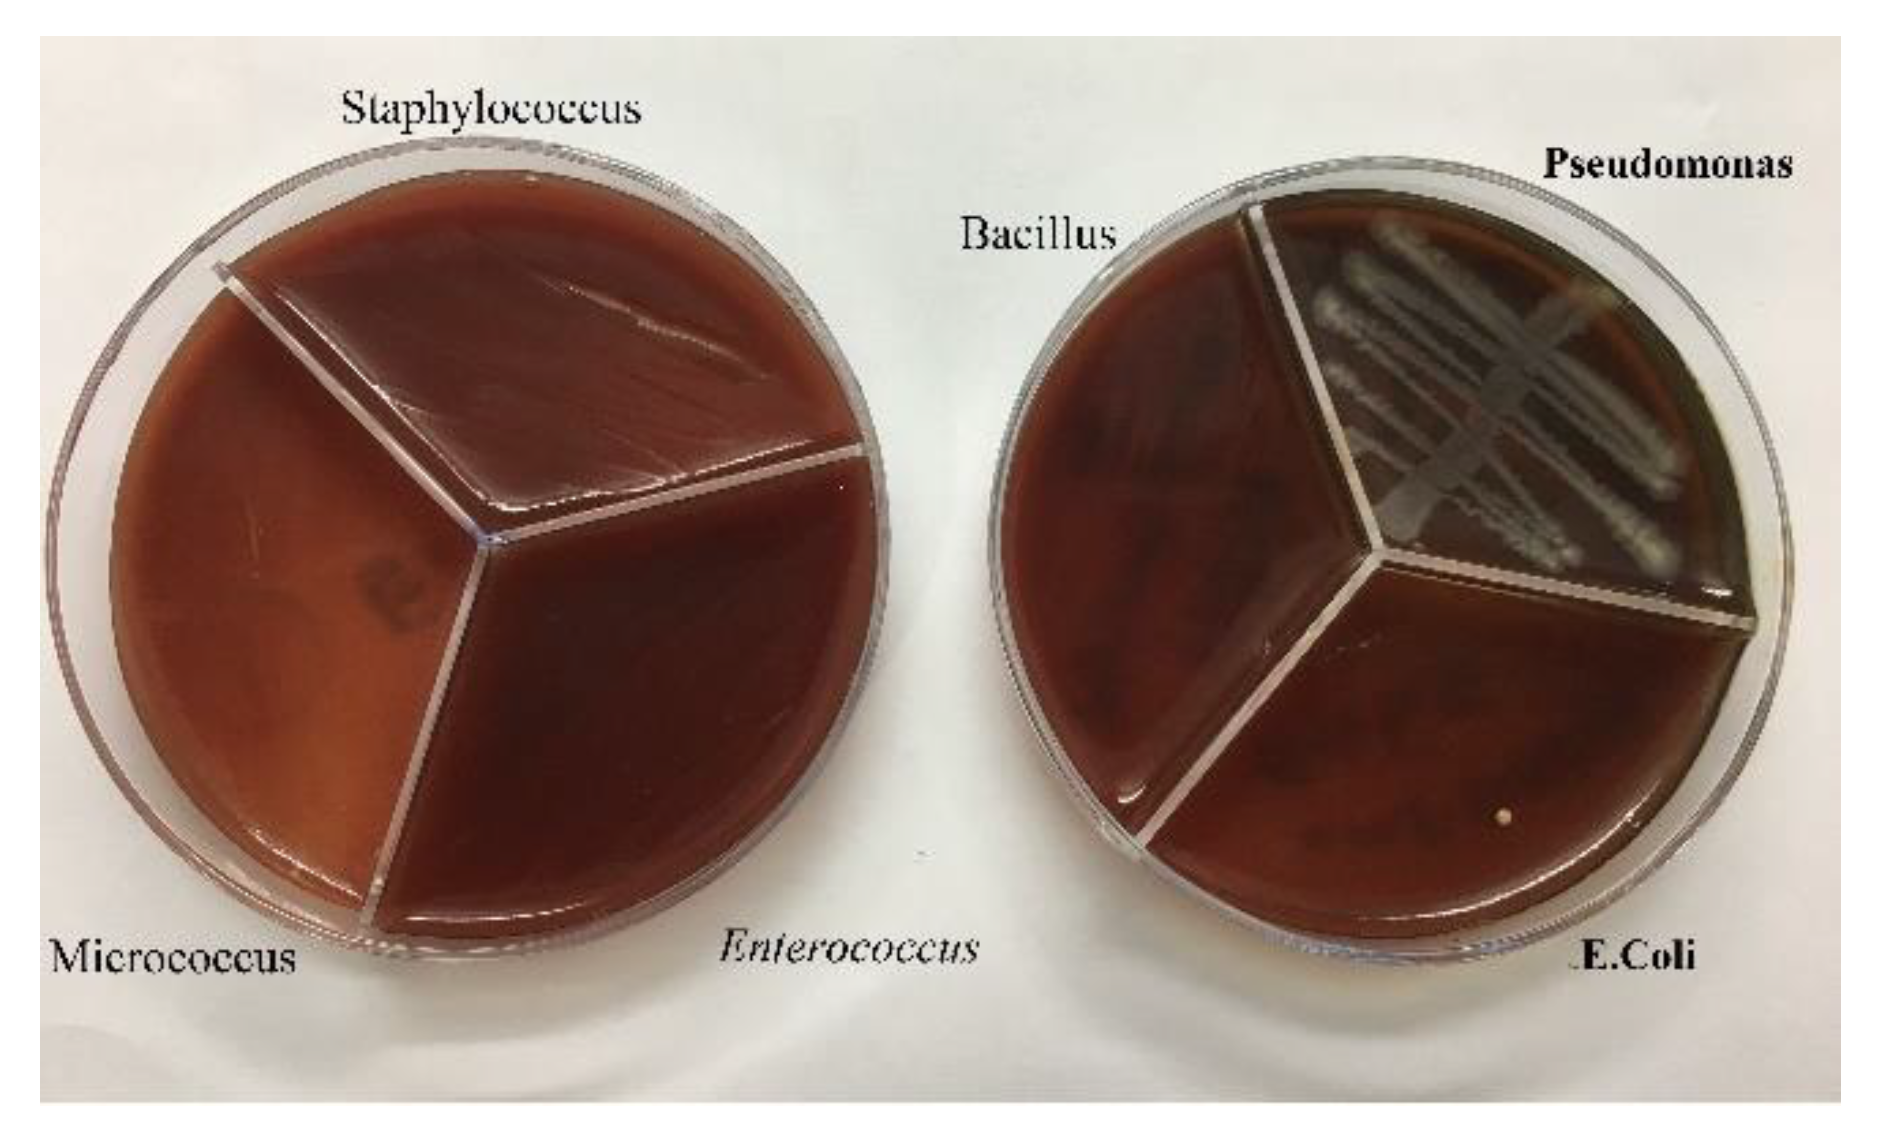
Preprints 85306 g008

1. Introduction
Nanotechnology is the manipulation of matter on an atomic, molecular, and supramolecular scale. The earliest, widespread description of nanotechnology [
8] referred to the particular technological goal of precisely manipulating atoms and molecules for fabrication of macroscale products, also now called molecular nanotechnology.
Nanotechnology As the nanoscale decreases in size, many properties of nonmaterial such as melting point phytochemical properties, boiling temperature, magnetic and chemical properties, light absorption, catalytic activity, thermal conductivity, and so on are changed. As the particle size of a material shrinks to a certain size, in addition to its structure and composition, its dimensions play an important role in its properties [9, 10].
Metal nano particles (MNPs) are protected by self-produced monolayers, leading to their increased application in areas such as adjustable optical devices [
11], sensor technologies [
4] and drug delivery [
12].
Nowadays, nano particles are widely used in drug delivery. Drug Delivery Systems (DDSs) are used to enhance the medicinal properties that are often contained in a drug as a reservoir. These structures are due to the control and slowdown of drug release, protection of the drug molecule, particle size smaller than the cell, the ability to cross biological barriers to drug delivery to the target site, increased drug viability in the bloodstream, targeted drug delivery and bioavailability. Compatibility can be considered as a very effective drug delivery system and thus affect the pharmacokinetics and drug distribution in the body. During the last half century, various advances in polymer science and chemistry, biology, as well as mechanical and physical sciences have all been able to introduce different categories of carriers to the medical sciences with unique characteristics and performance [
13].
With the advancement of the pharmaceutical sciences, more goals have been pursued in pharmacokinetics structures so that in addition to improving the pharmacotherapy, they can reduce drug side effects and also be economically viable. In common pharmaceutical systems, various compounds are used along with formulations, which increase the solubility of the drug molecule by creating changes in the environment, or by absorbing water in the environment, the possibility of dissolving the drug molecule. Increase. For example, environmentally friendly materials can be used to increase the dissolution of a molecule by creating a specific pH, or some polymers can increase the solubility of water by absorbing water. For example, liposomes are used in drug delivery to people with HIV, such as (siRNA) to human T cells [
14], as well as in the treatment and administration of anticancer drugs [
15], fungicides [
16], Antiparasitic drugs [
17], antibacterial drugs [
18], antiviral drugs [
19].
AgNPs are a significant class of nanomaterial for a wide range of industrial and biomedical applications. The unique chemical properties of AgNPs make it a promising targeted delivery approach for drugs or gene specific cells. With the improved use of AgNPs drug as a carrier and their predictable antibacterial property. Here, synthetic improvement in the preparation of drugs with NPs also is described.
2. Experimental
2.1. Material and Methods
Pure omeprazole and omeprazole sulfid, NaBH4 (99%), AgNO3 (99.9%), polyvinylpyrrolidone (PVP) were purchased from Merck. The FT-IR spectra for the samples were obtained using Spectrum Two spectrophotometer. The morphology and particle sizes of synthesized powder were characterized by transmission electron microscope (TEM) images on a Zeiss EM10C instrument with an accelerating voltage of 100 KV. The X-ray diffraction (XRD) patterns were recorded by X’ Pert Pro X-ray diffractometer with Cu-Ka radiation. UV-Vis absorption spectra in the range 200–500 nm in EtOH were measured with a Shimadzu UV-2550 spectrophotometer.
2.2. The Synthesis of NPs Whit Omeprazole and Omeprazole Sulfid (One-Put)
A solution of AgNO3 (0.082 g, 0.48 mmol) in ultrapure H2O (10 mL) was prepared. To this solution were added 0.03 g polyvinylpyrrolidone in 5.0 mL ultrapure H2O and then the mixture was stirred heavily for 30 min in an ice bath. A solution of NaBH4 (0.018 g, 0.48 mmol) in ultrapure H2O (6 mL) was added dropwise to the aqueous solution. On complete addition of NaBH4, the resulting mixture was further stirred for 30 min at room temperature. Then, a solution of omeprazole (0.331 g, 0.96 mmol) in EtOH (10 mL) was added to the reaction vessel, and then the mixture was stirred for further 4 h at this stage the color of solution was turned to dark brown.
The suspension obtained was then centrifuged at 10,000 rpm for 15 min and the precipitate washed three times with double distilled H2O to remove any water-soluble impurity. After that, the precipitate was washed 3 times by dispersion and centrifugation using EtOH to remove excess Omeprazole and excess reducing agent. The precipitate was then dried in an oven at 60 C for 10 h and the pale grey powder was obtained.
Figure 1.
Preparation of Ag@Omprazole sulfid.
Figure 1.
Preparation of Ag@Omprazole sulfid.
3. Results
In continuation to our interest in the design and synthesis of chemically and biologically medicinal heterocycles [1, 4, 5, 20-22], in this study, we attempted to functionalized AgNPs covalently with the Omeprazole (Ag@Omp).
The UV-Visible, IR, XRD, and TEM basic analyses confirm that silver is connected by the drug. In this study, both drugs, omeprazole, and omeprazole sulfide, and also a blend of two drugs, were put on a silver nanoparticle.
For the preparation of Ag@Omprazole arrangement of AgNO3 in ultrapure H2O and starch blending was included to the circular bottom flask. Subsequently, the expansion of an overabundance sum of NaBH4 as a decreasing operator. To reduce all of the Ag+ particles to metallic silver, the molar proportion of metal to the diminishing operator was chosen as 1:2 separately.
At that point, an EtOH arrangement of Omeprazole was included to the response vessel. The sulfur of Omeprazole ties emphatically to AgNPs surface. The arrangement of Ag@Omprazole was checked by examination to affirm that silver was associated to the medicate. In this blend, both drugs, omeprazole, and omeprazole sulfide, additionally a blend of two drugs, were set on a silver nanoparticle.
3.1. X-Ray Diffraction
The powder XRD designs of the Ag@Omp (a) and Ag@Omps (b) are appeared in
Figure 2. The crest position of the 2θ = 38˚- 80˚ (
Figure 2a). This design connected well with Ag@Omprazole. In
Figure 2b, the characteristic crests of AgNPs were at 2θ = 38˚-80˚ separately, relegated as (111), (200), and (220) reflection lines of the face-centered cubic (fcc) structure of metallic silver. The normal crystallite estimate, D, was calculated from Scherrer’s condition to be 58 nm in Ag@Omp (2a) and 28 nm in Ag@Omps (2b) whereas D= Kl/(β cosθ) and λ is the wavelength of Cu-Ka radiation utilized (λ = 1.54 A˚), β is the total width at half-maximum concentrated (0.31) of the diffraction line, θ is the Bragg point for the measured hKI peak, and K could be a consistent break even with to 0.94. This esteem is in great assention with the TEM picture. The escalated of crests reflected the tall degree of crystallinity of the AgNPs.
Figure 2.
X-ray diffraction patterns of the (a) Ag@Omp and (b) Ag@Omps.
Figure 2.
X-ray diffraction patterns of the (a) Ag@Omp and (b) Ag@Omps.
3.2. UV-Vis Absorption Spectra
Figure 3 outlines the UV-Vis assimilation spectra of Ag@Omp and Ag@Omps in EtOH arrangement. The unadulterated Omp appears as a λmax at 400 nm corresponding to the n
→η* move of the molecule O-Omp, while a solution of Ag@Omp appears as a λmax at 300 nm retention surface plasmon reverberation retention band (SPRAB) of AgNPs, individually. also, the unadulterated Omps appears as a λmax at 400 nm corresponding to the n
→η* move of the molecule S-Omps, whereas an arrangement of Ag@Omps appears as a λmax at 300 nm.
Figure 3.
UV-Vis absorption spectra of Ag@Omp and Ag@Omps , Ag@Omp-Omps.
Figure 3.
UV-Vis absorption spectra of Ag@Omp and Ag@Omps , Ag@Omp-Omps.
Within the final shap, UV-Vis assimilation spectra of Ag@Omp-Omps in EtOH arrangement. shows a λmax at 400 nm compared to the n→η* move of the molecule O-Omp and S-Omps assimilation surface plasmon reverberation retention band (SPRAB) of AgNPs. with compared to the assimilation band of free drugs at 400 nm, affirms a lower concentration of drugs on AgNPs. The appearance of two new peaks at 300 nm is related to the Ag-Drugs complex.
3.3. TEM Imaging
The TEM of Ag@Omp (fig 4a,b) image reveals that particles are spherical shape with approximate size of <40 nm; Scherrer’s calc. = 28 nm.
Figure 4.
TEM image of the (a,b) Ag@Omp , (c,d) Ag@Omps.
Figure 4.
TEM image of the (a,b) Ag@Omp , (c,d) Ag@Omps.
The TEM of Ag@Omps (fig 4c,d) image reveals that particles are spherical shape with approximate size of <60 nm; Scherrer’s calc. = 58 nm.
4. Antibacterial Properties
4.1. Materials and Methods
Agar Mueller Hinton, tube containing half McFarland, tube containing DMSO, antibiogram discs and pure bacteria in suitable culture medium, swab, loop, anus, flame, hood, lamp, The bacteria Pseudomonas, Staphylococcus, E. coli, Bacillus, Enterococcus and Micrococcus were used.
Several studies have been conducted on the therapeutic effects of omeprazole with antibiotics in patients with duodenal ulcer and Helicobacter pylori infection [
23].
In this study, to determine the antibacterial activities of Ag@Omp, Ag@Omps and Ag@Omp-Omps, MIC and disc diffusion methods were used.
4.2. Minimum Inhibitory Concentration (MIC) and Minimum Bactericidal Concentration (MBC)
To get ready the reference tube of drugs, 1 g of the Ag@Omp was broken up into 5 ml of DMSO. To decide the MIC, ten tubes containing 1 ml of Trypticase Soy Broth (TSB) were utilized. Within the first tube, 1 ml of the reference tube was poured. After blending, 1 ml of which was evacuated and poured into the second tube. This handle kept on reaching the tenth tube, and the final 1 ml of the tenth tube was picked out. Within the bacterial tube, 5×105 -106 (CFU)/ml colony-forming units were added to each tube. These tubes were brooded at 37°C for 18-24 hrs. Gram-positive (Staphylococcus aureus ATCC27853, Bacillus subtilis ATCC1715, Micrococcus luteus ATCC1408) and gram-negative (Pseudomonas aeruginosa ATCC1310, Escherichia coli ATCC25922, and Enterococcus faecalis ATCC29212) bacteria were used in this part. Subsequently, each tube was hacked and refined on an agar plate and hatched at 37°C for 18-24 hrs.
Figure 5.
Growth of bacteria in the presence of pure omeprazole.
Figure 5.
Growth of bacteria in the presence of pure omeprazole.
Figure 6.
Growth of bacteria in the presence of pure omeprazole sulfid.
Figure 6.
Growth of bacteria in the presence of pure omeprazole sulfid.
After culturing the bacteria on pure agar medium, this time the synthesis product namely silver-omeprazole and silver-omeprazole sulfide was cultured on agar medium. Although silver along with the drug caused low growth in some cases or no growth in others, which is the result in the pictures.
Figure 7.
Growth of bacteria with Ag-Omp.
Figure 7.
Growth of bacteria with Ag-Omp.
Figure 8.
Growth of bacteria with Ag-Omps.
Figure 8.
Growth of bacteria with Ag-Omps.
Figure 9.
Growth of bacteria with mix Ag-drugs.
Figure 9.
Growth of bacteria with mix Ag-drugs.
4.3. Disc Diffusion
To characterize the hindrance zone for microbes utilized in this consider, the circle dissemination strategy was utilized. For this reason, 0.5 McFarland tubes of microscopic organisms were arranged and refined on agar plates. Within the another step, the circles were filled with 30, 40, 50, and 60 µl of reference tube. At long last, the plates were hatched at 37°C for 18-24 hrs.
It can be concluded that the Omp and Omps alone don't have an antibacterial impact, but, by combining them with silver, it makes strides the impact.
The higher the diameter of the non-growth halo is due to the performance of the drug. In the Ag @ OMP-OMPS test, dilution 0.2 is the lowest concentration in the growth halo (
Table 1).
Minimum inhibitory concentration (MIC) and the minimum concentration of bacteria (MBC) in this study was not desirable because the solution inside the tubes was foggy and their detection was not feasible.
5. Discussion
At a glance, the silver nanoparticle synthesis with the drug omeprazole and omeprazole sulfide, as well as the combination of the two drugs, was successful. Even the synthesis of a mixture of drugs had the expected result. In this study, silver nanoparticles were able to increase the bacterial properties of the drugs associated with it and improve the properties of the drug.
Omeprazole sulfide is much more successful than silver omeprazole in schnitzel with silver nanoparticles and has also shown better antibacterial properties. The mixture of the two drugs was also moderate compared to omeprazole.
Due to the diameter of the bacteria's lack of growth, it can be concluded that the Ag@Omp and Ag@Omps alone does not have an antibacterial effect, but, by combining with silver, it improves the effect. The higher the diameter of the non-growth halo is due to the performance of the drug. In the Ag @ OMP-OMPS test, dilution 0.2 is the lowest concentration in the growth halo(table 1).
6. Conclusions
The considerations have uncovered that AgNPs had anti-inflammatory, antibacterial, and antifungal properties. In this consideration, we coated synthesized AgNPs with omeprazole and omeprazole sulfide to investigate their antibacterial and antifungal proficiency. In reality, the expansion of AgNPs on drugs may demonstrate to be an amazing elective. The sulfur of omeprazole and omeprazole sulfide ties unequivocally to the AgNPs surface by self-assembly as affirmed by FT-IR, UV-Vis, and TEM. This nanostructure may give an advantage demonstrate a framework for the advancement of modern viable nano-drug.
References
- Mahmoodi, N.O.; Ghavidast, A.; Amirmahani, N. A comparative study on the nanoparticles for improved drug delivery systems. J. Photochem. Photobiol. B: Biol. 2016, 162, 681–693. [Google Scholar] [CrossRef] [PubMed]
- Ghavidast, A.; Mahmoodi, N.O.; Zanjanchi, M.A. Synthesis and photochromic properties of a novel thiol-terminated 1,3-diazabicyclo[3.1.0]hex-3-ene on silver nanoparticles. J. Mol. Struct. 2013, 1048, 166–171. [Google Scholar] [CrossRef]
- Mahmoodi, N.O., et al., Efficient Synthesis of (S)-(+)-Clopidogrel Bisulfate-Capped Silver Nanoparticles. Synthesis and Reactivity in Inorganic, Metal-Organic, and Nano-Metal Chemistry, 2016. 46(10): p. 1552-1557. [CrossRef]
- Ghavidast, A.; Mahmoodi, N.O.; Zanjanchi, M.A. Synthesis and photochromic properties of disulfide-1,3-diazabicyclo[3.1.0]hex-3-ene functionalized silver nanoparticles. J. Mol. Liq. 2014, 198, 128–133. [Google Scholar] [CrossRef]
- Mahmoodi, N.O.; Aghajani, N.; Ghavidast, A. Synthesis and photochromic properties of thiolated N-salicylidene-anilines on silver nanoparticles. J. Mol. Struct. 2017, 1128, 21–29. [Google Scholar] [CrossRef]
- Mahmoodi, N.O., et al., Photochromism of azobenzene-thiol-1, 3-diazabicyclo-[3.1. 0] hex-3-ene on silver nanoparticles. Dyes and Pigments, 2015. 118: p. 110-117. [CrossRef]
- Chabner, B.A.; Roberts, T.G., Jr. Timeline: Chemotherapy and the war on cancer. Nat. Rev. Cancer 2005, 5, 65–72. [Google Scholar] [CrossRef]
- Drexler, E., The coming era of nanotechnology. Whole Earth Review, 1986. 27.
- Ahmad, Z.; Pandey, R.; Sharma, S.; Khuller, G.K. Alginate nanoparticles as antituberculosis drug carriers: formulation development, pharmacokinetics and therapeutic potential. Indian J. chest Dis. Allied Sci. 2006, 48, 171. [Google Scholar]
- Gong, P., et al., Preparation and antibacterial activity of Fe3O4@ Ag nanoparticles. Nanotechnology, 2007. 18(28): p. 285604.
- Malcher, M.; Volodkin, D.; Heurtault, B.; André, P.; Schaaf, P.; Möhwald, H.; Voegel, J.-C.; Sokolowski, A.; Ball, V.; Boulmedais, F.; et al. Embedded Silver Ions-Containing Liposomes in Polyelectrolyte Multilayers: Cargos Films for Antibacterial Agents. Langmuir 2008, 24, 10209–10215. [Google Scholar] [CrossRef] [PubMed]
- Shipway, A.N., E. Katz, and I. Willner, Nanoparticle arrays on surfaces for electronic, optical, and sensor applications. ChemPhysChem, 2000. 1(1): p. 18-52. [CrossRef]
- Tong, H.-I.; Kang, W.; Shi, Y.; Zhou, G.; Lu, Y. Physiological function and inflamed-brain migration of mouse monocyte-derived macrophages following cellular uptake of superparamagnetic iron oxide nanoparticles—Implication of macrophage-based drug delivery into the central nervous system. Int. J. Pharm. 2016, 505, 271–282. [Google Scholar] [CrossRef] [PubMed]
- Garrigue, J.-S., G. Lambert, and S. Benita, Self-emulsifying oral lipidbased formulations for improved delivery of lipophilic drugs. Microencapsulation: Methods and Industrial Applications, 2006. 2: p. 429-480.
- Liu, Z.; Winters, M.; Holodniy, M.; Dai, H. siRNA Delivery into Human T Cells and Primary Cells with Carbon-Nanotube Transporters. Angew. Chem. Int. Ed. 2007, 46, 2023–2027. [Google Scholar] [CrossRef] [PubMed]
- Minko, T., et al., New generation of liposomal drugs for cancer. Anti-Cancer Agents in Medicinal Chemistry (Formerly Current Medicinal Chemistry-Anti-Cancer Agents), 2006. 6(6): p. 537-552.
- Anaissie, E.; Paetznick, V.; Proffitt, R.; Adler-Moore, J.; Bodey, G.P. Comparison of the in vitro antifungal activity of free and liposome-encapsulated amphotericin B. Eur. J. Clin. Microbiol. Infect. Dis. 1991, 10, 665–668. [Google Scholar] [CrossRef]
- Date, A.A.; Joshi, M.D.; Patravale, V.B. Parasitic diseases: Liposomes and polymeric nanoparticles versus lipid nanoparticles. Adv. Drug Deliv. Rev. 2007, 59, 505–521. [Google Scholar] [CrossRef]
- Barani, H.; Montazer, M.; Toliyat, T.; Samadi, N. Synthesis of Ag-liposome nano composites. J. Liposome Res. 2009, 20, 323–329. [Google Scholar] [CrossRef]
- Ghavidast, A.; Mahmoodi, N.O. A comparative study of the photochromic compounds incorporated on the surface of nanoparticles. J. Mol. Liq. 2016, 216, 552–564. [Google Scholar] [CrossRef]
- Mahmoodi, N.O.; Mirkhaef, S.; Ghavidast, A. Synthesis of anthracene derivatives of 1,3-diazabicyclo[3.1.0]hex-3-ene. J. Mol. Struct. 2015, 1081, 248–253. [Google Scholar] [CrossRef]
- Mahmoodi, N.; Tabatabaeian, K.; Ghavidast, A. Synthesis and photochromic behavior of mono-, and biphotochromic system linked by p-phenylene bridge. Chin. Chem. Lett. 2010, 21, 1199–1202. [Google Scholar] [CrossRef]
- Nazifii, A., Effect of omeprazole plus ciprofloxacin on healing of duodenal ulcer and eradication of Helicobacter pylori. Razi Journal of Medical Sciences, 2001. 8(25): p. 334-338.
|
Disclaimer/Publisher’s Note: The statements, opinions and data contained in all publications are solely those of the individual author(s) and contributor(s) and not of MDPI and/or the editor(s). MDPI and/or the editor(s) disclaim responsibility for any injury to people or property resulting from any ideas, methods, instructions or products referred to in the content. |
© 2023 by the authors. Licensee MDPI, Basel, Switzerland. This article is an open access article distributed under the terms and conditions of the Creative Commons Attribution (CC BY) license (http://creativecommons.org/licenses/by/4.0/).